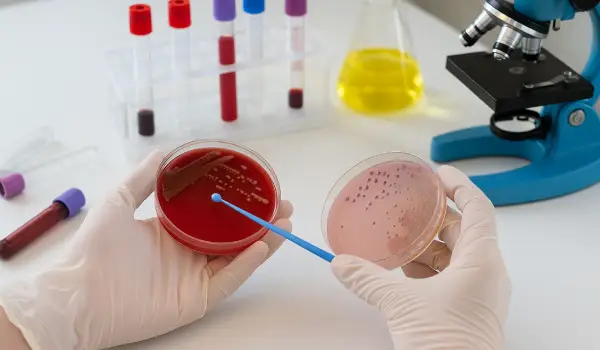
مراحل کشت زخم

عفونت زخم، خاموش و خزنده آغاز میشود اما میتواند با سرعتی باورنکردنی به یک بحران سیستمیک تبدیل شود. برای یک بیمار دیابتی یا فردی که دچار زخم بستر است، تفاوت بین “بهبودی” و “قطع عضو”، گاهی تنها در یک تشخیص درست و بهموقع نهفته است. در دنیای درمان زخم، چشمپوشی از علائم عفونت یا درمان کورکورانه با آنتیبیوتیکهای عمومی، بزرگترین اشتباهی است که میتوان مرتکب شد.
اینجاست که “آزمایش کشت زخم (Wound Culture)” به عنوان قطبنمای درمان وارد عمل میشود. در کلینیک زخم اهواز، ما معتقدیم که درمان زخم بدون شناخت دقیق باکتری عامل عفونت، مانند تیراندازی در تاریکی است. این مقاله جامع، هر آنچه را که باید درباره کشت زخم، نحوه انجام آن، تفسیر نتایج و اهمیت حیاتی آن بدانید، در اختیار شما قرار میدهد. اگر ساکن اهواز یا استانهای جنوبی کشور هستید و با زخمی که خوب نمیشود دست و پنجه نرم میکنید، این مطلب نقشه راه شماست.
کشت زخم چیست؟ (فراتر از یک آزمایش ساده)
کشت زخم یک تست آزمایشگاهی تشخیصی است که در آن نمونههایی از بافت، مایعات یا چرک محل زخم برداشته شده و در محیطهای مخصوص کشت باکتری قرار میگیرند تا میکروارگانیسمهای عامل عفونت شناسایی شوند.
اما این تنها نیمی از ماجراست. بخش دوم و شاید مهمتر این فرآیند، تست حساسیت آنتیبیوتیکی یا آنتیبیوگرام (Antibiogram) است. پس از اینکه باکتری شناسایی شد، در آزمایشگاه بررسی میشود که کدام آنتیبیوتیکها قادر به کشتن آن هستند و باکتری نسبت به کدام داروها مقاوم شده است.
چرا “نگاه کردن” به زخم کافی نیست؟
بسیاری از بیماران میپرسند: “آقای دکتر، زخم من قرمز شده و چرک دارد، چرا فقط پنیسیلین نمیدهید؟” پاسخ در پیچیدگی باکتریهاست. ظاهر یک زخم عفونی ناشی از باکتری “استافیلوکوک طلایی” ممکن است دقیقاً شبیه زخمی باشد که توسط “سودوموناس” (عامل عفونت بیمارستانی) ایجاد شده است. اما درمان این دو کاملاً متفاوت است. تجویز اشتباه آنتیبیوتیک نه تنها عفونت را درمان نمیکند، بلکه باعث میشود باکتریها قویتر شده و به اصطلاح “مقاوم” شوند.

چه زمانی پزشک دستور کشت زخم میدهد؟ (علائم هشدار)
در کلینیک زخم اهواز، متخصصان ما برای هر خراش کوچکی کشت انجام نمیدهند. کشت زخم زمانی ضروری است که علائم بالینی عفونت مشاهده شود یا روند ترمیم زخم متوقف شده باشد. اگر علائم زیر را دارید، شما کاندیدای اصلی این آزمایش هستید:
- ترشحات چرکی: خروج مایع زرد، سبز یا قهوهای بدبو از زخم.
- بوی نامطبوع: بویی شبیه به گوشت فاسد یا بوی شیرین و زننده (که معمولاً نشانه عفونت سودوموناس است).
- گرما و قرمزی گسترش یابنده: اگر قرمزی اطراف زخم روز به روز بیشتر میشود (سلولیت).
- درد فزاینده: زخمی که قبلاً درد نداشت اما ناگهان دردناک شده است.
- توقف روند بهبودی: زخمی که با وجود مراقبتهای معمول، پس از ۳۰ روز هیچ پیشرفتی نکرده است.
- علائم سیستمیک: تب، لرز، تهوع یا بالا رفتن گلبولهای سفید خون (WBC) در آزمایش خون.
انواع روشهای نمونهگیری کشت زخم (استانداردهای طلایی)
دقت آزمایش کشت زخم، ۱۰۰٪ وابسته به نحوه نمونهگیری است. اگر نمونهگیری غلط انجام شود، باکتریهای بیخطر روی پوست (فلور نرمال) به اشتباه به عنوان عامل عفونت شناسایی میشوند. در کلینیک زخم اهواز، ما از سه روش استاندارد جهانی استفاده میکنیم:
۱. روش سواپ (Swab Culture) – تکنیک لوین (Levine Technique)
این رایجترین و کمتهاجمیترین روش است، اما اگر درست انجام نشود، بیارزشترین نتایج را میدهد.
- چگونه انجام میشود؟ ابتدا زخم باید کاملاً با سرم شستشو تمیز شود تا ترشحات سطحی و بافت مرده پاک شوند (این مرحله حیاتی است). سپس سواپ (که شبیه گوشپاککن استریل است) با فشار کافی روی سالمترین و تمیزترین بافت بستر زخم (نه روی چرکها!) چرخانده میشود تا مایع بافتی جذب شود. فشار باید به اندازهای باشد که کمی خونابه خارج شود.
۲. آسپیراسیون سوزنی (Needle Aspiration)
این روش برای زخمهای حفرهدار، آبسههای بسته و عفونتهای زیرپوستی استفاده میشود.
- چگونه انجام میشود؟ پزشک پس از ضدعفونی کردن پوست سالم اطراف زخم، یک سوزن استریل را وارد حفره یا تجمع مایع کرده و مایع را به داخل سرنگ میکشد. این روش خطر آلودگی با باکتریهای پوست را به صفر میرساند و برای تشخیص باکتریهای بیهوازی (که در مجاورت هوا میمیرند) عالی است.
۳. بیوپسی بافت (Tissue Biopsy) – استاندارد طلایی
این دقیقترین روش تشخیص عفونت زخم در جهان است که در موارد پیچیده و زخمهای مزمن دیابتی در کلینیک زخم اهواز انجام میشود.
- چگونه انجام میشود؟ قسمتی از بافت زنده عمق زخم (نه بافت مرده سطحی) به روش جراحی برداشته میشود. این بافت در آزمایشگاه خرد شده و کشت داده میشود. بیوپسی تنها راهی است که نشان میدهد آیا باکتریها واقعاً به بافت حمله کردهاند یا فقط روی سطح زخم زندگی میکنند.
مراحل انجام کشت زخم در کلینیک زخم اهواز؛ گام به گام
بیماران اغلب نگران درد یا پیچیدگی این فرآیند هستند. بیایید دقیقاً ببینیم وقتی برای کشت زخم مراجعه میکنید چه اتفاقی میافتد:
مرحله اول: آمادهسازی و دبریدمان (Debridement)
مهمترین قانون آزمایشگاه میکروبیولوژی این است: “آشغال وارد شود، آشغال خارج میشود.” اگر از روی چرک و بافت مرده نمونه بگیریم، نتیجه غلط خواهد بود. بنابراین، کارشناسان زخم ما ابتدا با دقت کامل، بافتهای نکروزه (سیاه) و اسلاف (زرد) را از روی زخم برمیدارند و زخم را با سرم نرمال سالین شستشو میدهند.
مرحله دوم: نمونهگیری استریل
بسته به نوع زخم شما (سطحی یا عمیق)، یکی از روشهای بالا انتخاب میشود. در این مرحله از تکنیکهای آسپتیک (کاملاً استریل) استفاده میشود تا هیچ باکتری محیطی وارد نمونه نشود.
مرحله سوم: انتقال فوری
باکتریها موجودات حساسی هستند. نمونه باید در کمتر از ۱ تا ۲ ساعت در محیطهای نگهدارنده مخصوص به آزمایشگاه معتبر طرف قرارداد ما در اهواز برسد. تاخیر در انتقال میتواند باعث مرگ باکتریهای مهم و رشد باکتریهای مزاحم شود.
باکتریهای رایج در زخمهای دیابتی و بستر
در آزمایشگاه، ما معمولاً به دنبال چه هستیم؟ شناخت دشمن، نیمی از پیروزی است.
- استافیلوکوک اورئوس (Staphylococcus aureus): شایعترین باکتری. نوع خطرناک آن یعنی MRSA (مقاوم به متیسیلین) کابوس بیمارستانهاست و به بسیاری از آنتیبیوتیکهای معمولی پاسخ نمیدهد.
- سودوموناس آئروژینوزا (Pseudomonas aeruginosa): باکتری فرصتطلب که ترشحات سبز رنگ و بوی خاصی تولید میکند. این باکتری عاشق محیطهای مرطوب است و در زخمهای سوختگی و مزمن بسیار دیده میشود.
- اشریشیا کلی (E. coli) و انتروکوکها: این باکتریها معمولاً از دستگاه گوارش نشأت میگیرند و در زخم بستر (ناحیه ساکروم یا دنبالچه) به دلیل نزدیکی به مقعد، بسیار شایع هستند.
- باکتریهای بیهوازی: این باکتریها در عمق زخمهایی که اکسیژن به آنجا نمیرسد (مثل زخمهای پای دیابتی عمیق) رشد میکنند و باعث بوی تعفن شدید و تولید گاز در بافت (گانگرن گازی) میشوند.
تفسیر نتایج کشت زخم؛ کلید درمان
پس از ۴۸ تا ۷۲ ساعت، جواب آزمایش آماده میشود. تفسیر این برگه کار متخصص عفونی و پزشک زخم است، اما دانستن کلیات آن برای شما مفید است:
- نتیجه منفی (No Growth): یعنی هیچ باکتری مضری رشد نکرده است. (البته اگر آنتیبیوتیک مصرف میکردید، ممکن است نتیجه کاذب باشد).
- نتیجه مثبت (Positive): نام باکتری و تعداد آن (Colony Count) ذکر میشود.
- جدول آنتیبیوگرام: این مهمترین بخش است. روبروی نام هر آنتیبیوتیک یکی از کلمات زیر نوشته شده:
- S (Sensitive): حساس. یعنی این دارو باکتری را میکشد. (داروی انتخابی ما خواهد بود).
- R (Resistant): مقاوم. یعنی این دارو هیچ اثری ندارد (خوردن آن فقط پول دور ریختن و عوارض جانبی است).
- I (Intermediate): نیمه حساس. یعنی دارو ممکن است با دوز بالا اثر کند، اما انتخاب اول نیست.
نکته حیاتی کلینیک زخم اهواز: بسیاری از بیماران با کیسهای پر از دارو مراجعه میکنند که هیچکدام روی باکتری زخمشان اثر ندارد (چون باکتری R یا مقاوم است). کشت زخم جلوی این درمانهای بیفایده را میگیرد.
آمادگیهای لازم قبل از انجام آزمایش کشت زخم
برای اینکه دقیقترین نتیجه را بگیرید، رعایت نکات زیر توسط بیمار ضروری است:
- عدم مصرف آنتیبیوتیک (در صورت امکان): ایدهآل این است که نمونهگیری قبل از شروع هرگونه آنتیبیوتیک (خوراکی یا تزریقی) انجام شود. اگر آنتیبیوتیک مصرف میکنید، حتماً به پزشک اطلاع دهید؛ گاهی لازم است ۴۸ ساعت دارو قطع شود یا نوع خاصی از محیط کشت استفاده شود.
- تمیز نکردن زخم در خانه قبل از مراجعه: اجازه دهید مراحل شستشو و دبریدمان به صورت تخصصی در کلینیک انجام شود. استفاده از بتادین یا پمادهای آنتیبیوتیک قبل از نمونهگیری، نتیجه را خراب میکند.
- ناشتا بودن لازم نیست: برخلاف آزمایش خون، برای کشت زخم نیازی به ناشتایی ندارید.
چرا کلینیک زخم اهواز؟ (مزیت رقابتی ما)
درمان زخم عفونی یک کار تیمی است. چرا بیماران از سراسر خوزستان و استانهای همجوار برای درمان عفونتهای پیچیده به مرکز ما مراجعه میکنند؟
- تیم چند تخصصی: ما فقط “پانسمان” عوض نمیکنیم. تیم ما شامل متخصص عفونی (برای تجویز دقیق دارو)، جراح (برای دبریدمان وسیع در صورت نیاز) و کارشناسان ارشد زخم است.
- تجهیزات نمونهگیری پیشرفته: ما از روشهای تهاجمی دقیق مثل بیوپسی پانچ در موارد مشکوک استفاده میکنیم که دقت تشخیصی بسیار بالاتری نسبت به سواپهای معمولی دارد.
- ارتباط مستقیم با آزمایشگاههای پاتوبیولوژی برتر اهواز: نمونههای ما در اولویت بررسی دقیق قرار دارند و نتایج آنتیبیوگرام به سرعت به دست تیم درمانی میرسد.
- درمانهای مکمل: پس از مشخص شدن نوع باکتری، ما از درمانهای نوین مثل اوزونتراپی و پلاسما تراپی استفاده میکنیم که مستقیماً دیواره سلولی باکتریها (حتی انواع مقاوم) را تخریب میکنند.
سوالات متداول بیماران (FAQ)
۱. آیا نمونهگیری از زخم درد دارد؟
روش سواپ معمولاً دردناک نیست، فقط ممکن است کمی فشار احساس کنید. در روشهای بیوپسی یا آسپیراسیون، از بیحسی موضعی استفاده میکنیم تا بیمار هیچ دردی حس نکند.
۲. چقدر طول میکشد تا جواب حاضر شود؟
کشت اولیه معمولاً ۲۴ تا ۴۸ ساعت زمان میبرد. اما تعیین حساسیت آنتیبیوتیکی (آنتیبیوگرام) ممکن است تا ۷۲ ساعت طول بکشد. برای باکتریهای خاص (مثل سل یا قارچها) این زمان طولانیتر است.
۳. آیا خودم میتوانم در خانه از زخم نمونه بگیرم و به آزمایشگاه ببرم؟
خیر، اکیداً توصیه نمیشود. نمونهگیری غیر استریل باعث آلوده شدن نمونه با میکروبهای دست، محیط خانه یا پوست اطراف زخم میشود و نتیجه آزمایش کاملاً غلط خواهد بود.
۴. اگر نتیجه کشت منفی بود اما زخم هنوز چرک داشت، چه کنیم؟
این حالت ممکن است به دلیل وجود “بیوفیلم” (لایه محافظ باکتریها) باشد که مانع از ورود باکتری به سواپ شده است، یا اینکه باکتری بیهوازی بوده و در انتقال از بین رفته است. در این موارد، متخصصین ما در کلینیک زخم اهواز روش نمونهگیری را تغییر داده (بیوپسی) و درمانهای ضد بیوفیلم را آغاز میکنند.
۵. هزینه آزمایش کشت زخم چقدر است؟
هزینه بسته به نوع آزمایش (هوازی، بیهوازی، قارچی) و تعرفه آزمایشگاه متفاوت است. اما این هزینه در برابر هزینه بستری شدن در بیمارستان به دلیل عفونت خون (سپسیس) یا قطع عضو، ناچیز است.
کلام آخر: زمان، دشمن زخمهای عفونی است
عفونت منتظر شما نمیماند. باکتریها هر ۲۰ دقیقه تکثیر میشوند و میتوانند یک زخم ساده را در عرض چند روز به استخوان برسانند (استئومیلیت). آزمایش کشت زخم، چشم بینای پزشک برای مبارزه با این دشمنان میکروسکوپی است.
اگر شما یا عزیزانتان با زخمی درگیر هستید که تغییر رنگ داده، بوی بد گرفته یا درمان نمیشود، جای هیچگونه آزمون و خطایی نیست. کلینیک زخم اهواز با بهرهگیری از دانش روز و پروتکلهای دقیق تشخیصی، آماده است تا قبل از اینکه دیر شود، روند درمان هدفمند شما را آغاز کند.
سلامتی پاهای شما، ماموریت ماست. همین امروز برای مشاوره و بررسی زخم خود با ما تماس بگیرید.
کلینیک زخم اهواز
پیشرو در تشخیص و درمان زخمهای مزمن در جنوب غرب کشور